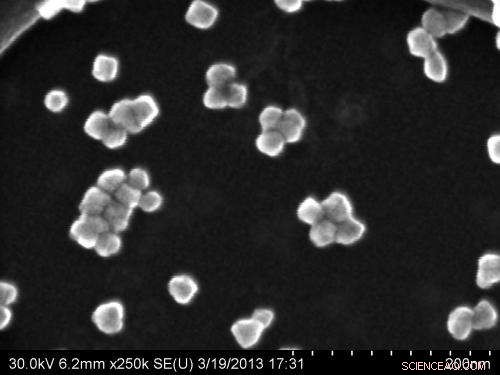
Innovative Nanoparticles Cut Solar Cell Production Costs

Nanoparticles made by University of Alberta researchers from Earth-abundant elements phosphorus and zinc, means solar cells can be made more affordably. Credit: University of Alberta
University of Alberta researchers have found that abundant materials in the Earth's crust can be used to make inexpensive and easily manufactured nanoparticle-based solar cells.
The U of A discovery, several years in the making, is an important step forward in making solar power more accessible to parts of the world that are off the traditional electricity grid or face high power costs, such as the Canadian North, said researcher Jillian Buriak, a chemistry professor and senior research officer of the National Institute for Nanotechnology, based on the U of A campus.
Buriak and her team have designed nanoparticles that absorb light and conduct electricity from two very common elements: phosphorus and zinc. Both materials are more plentiful than scarce materials such as cadmium and free from manufacturing restrictions imposed on lead-based nanoparticles.
"Half the world already lives off the grid, and with demand for electrical power expected to double by the year 2050, it is important that renewable energy sources like solar power are made more affordable by lowering the costs of manufacturing," Buriak said.
Her team's research supports a promising approach of making solar cells cheaply using mass manufacturing methods like roll-to-roll printing (as with newspaper presses) or spray-coating (similar to automotive painting). "Nanoparticle-based 'inks' could be used to literally paint or print solar cells or precise compositions," Buriak said.
The team was able to develop a synthetic method to make zinc phosphide nanoparticles and demonstrated that the particles can be dissolved to form an ink and processed to make thin films that are responsive to light.
Buriak and her team are now experimenting with the nanoparticles, spray-coating them onto large solar cells to test their efficiency. The team has applied for a provisional patent and has secured funding to enable the next step to scale-up manufacture.
The research, which was supported by the Natural Sciences and Engineering Research Council of Canada, is published in the latest issue of ACS Nano.